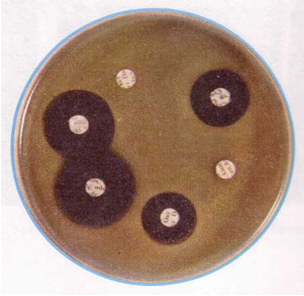

Материал: Методическое пособие. Общая микробиология
Минимальная подавляющая концентрация (МПК) - наименьшая концентрация антибиотика (мг/л или мкг/мл), которая in vitro полностью подавляет видимый рост бактерий

Рис. 1. Определение значения МПК методом разведения в жидкой питательной среде.
в) Определение чувствительности микроорганизма с помощью Е-теста проводится аналогично тестированию диско-диффузионным методом. Отличие состоит в том, что вместо диска с антибиотиком используют полоску Е-теста, содержащую градиент концентраций антибиотика от максимальной к минимальной (рис. 3). В месте пересечения эллипсовидной зоны подавления роста с полоской Е-теста получают значение минимальной подавляющей концентрации (МПК).
Несомненным достоинством диффузионных методов является простота тестирования и доступность выполнения в любой бактериологической лаборатории. Однако с учетом высокой стоимости Е-тестов для рутинной работы обычно используют диско-диффузионный метод.
|
|
|
|
Рис. 2. Зоны задержки роста при дисковом методе определения чувствительности к антибиотикам |
Рис. 3. Определение чувствительности микроорганизмов с помощью Е-тестов |
Контрольные вопросы
В чем сущность определения чувствительности бактерий к антибиотикам?
Какие методы используются для определения чувствительности микроорганизмов к антибиотикам?
В чем заключается метод дисков?
Как учитывается чувствительность к антибиотикам методом дисков?
Что позволяет определить метод серийных разведений?
Что означает минимальная подавляющая концентрация?
В чем заключаются преимущества и недостатки Е-теста?
Какие существуют особенности механизма действия антибиотиков?
Какие типы лекарственной устойчивости вы знаете?
Что такое антибиотикорезистентность и механизмы ее формирования?
Приложение к ЗАНЯТИЮ 13.
Механизм действия антибиотиков
Всем антибиотикам свойственна избирательность действия. Их относительная безвредность для человека определяется прежде всего тем, что они специфически подавляют такие метаболические процессы в микробной клетке или у вируса, которые отсутствуют в эукариотной клетке или не доступны для них. В этом отношении уникален механизм действия бета-лактамных антибиотиков. Мишенями для них являются транспептидазы, которые завершают синтез пептидогликана клеточной стенки. Поскольку клеточная стенка есть только у прокариот, в эукариотной клетке нет мишеней для бета-лактамных антибиотиков. Транспептидазы представляют собой набор белков-ферментов, локализованных в цитоплазматической мембране бактериальной клетки. Отдельные бета-лактамы различаются по степени сродства к тому или иному ферменту, которые получили название пенициллинсвязывающих белков. Поэтому биологический эффект бета-лактамных антибиотиков различен от бактериостатического до бактерицидного, литического.
Кроме бета-лактамных антибиотиков, синтез клеточной стенки нарушают такие антибиотики, как бацитрацин, фосфомицин, циклосерин. ванкомицин, ристомицин, однако иным путем, чем пенициллин. Все они, кроме циклосерина, вызывают бактерицидный эффект.
Механизм действия таких антибиотиков, как хлорамфеникол, тетрациклины, стрептомицин, аминогликозиды, эритромицин, олеандомицин, спирамицин и другие макролиды, линкозамиды, фузидиевая кислота, пуромицин, связан с угнетением синтеза белка на уровне рибосом 70S. Хотя бактериальные рибосомы 70S имеют такую же в принципе структуру, как рибосомы 80S эукариотных клеток, их белки и белковые факторы, участвующие в работе белоксинтезирующей системы, отличаются от таковых рибосом 80S. Этим и объясняется избирательность действия указанных антибиотиков на белковый синтез бактерий.
Антибиотики по-разному блокируют синтез белка. Тетрациклины блокируют связывание аа-тРНК на А-участке рибосомы 70S. Хлорамфеникол подавляет пепти-дилтрансферазную реакцию. Стрептомицины препятствуют превращению инициа-торного комплекса в функционально активную рибосому. Эритромицин блокирует реакцию транслокации. Пуромицин, присоединяясь к растущему концу синтезируемой полипептидной цепи, вызывает преждевременное отделение ее от рибосомы. Механизм действия фторхинолонов связан с избирательным подавлением ими бактериальных ферментов ДНК-гираз, участвующих в репликации ДНК. Фторхинолоны связываются со специфическими участками ДНК, которые создаются под воздействием ДНК-гиразы, и подавляют ее активность.
Рифампицины угнетают активность ДНК-зависимых РНК-полимераз, вследствие чего у бактерий подавляются процессы транскрипции.
Активность противоопухолевых антибиотиков связана с тем, что они либо подавляют синтез ДНК (брунеомицин), либо подавляют активность ДНК в системе ДНК-зависимой РНК-полимеразы, т. е. блокируют транскрипцию (антрациклины, актиномицины, оливомицин).
Лекарственная устойчивость бактерий
Существуют два типа лекарственной устойчивости бактерий: естественная, или природная, и приобретенная.
Естественная лекарственная устойчивость является видовым признаком. Она присуща всем представителям данного вида и не зависит от первичного контакта (контактов) с данным антибиотиком, в ее основе нет никаких специфических механизмов. Чаще всего эта резистентность связана с недоступностью мишеней для данного антибиотика, обусловленной очень слабой проницаемостью клеточной стенки и цитоплазматической мембраны, или какими-либо другими причинами. Если низкая проницаемость свойственна нескольким антибиотикам, то она будет обусловливать полирезистентность таких бактерий.
Приобретенная лекарственная устойчивость возникает у отдельных представителей данного вида бактерий только в результате изменения их генома. Возможны два варианта генетических изменений. Один из них связан с мутациями в тех или иных генах бактериальной хромосомы, вследствие которых продукт атакуемого гена перестает быть мишенью для данного антибиотика. Это происходит либо вследствие изменения структуры белка, либо потому, что он становится недоступным для антибиотика.
В другом случае бактерии становятся устойчивыми к антибиотику или даже сразу к нескольким антибиотикам благодаря приобретению дополнительных генов, носителями которых являются R-плазмиды. Никаких других механизмов приобретенной лекарственной устойчивости не существует. Однако, приобретая устойчивость к антибиотику, а тем более сразу к нескольким антибиотикам, такие бактерии получают наивыгоднейшие преимущества: благодаря селективному давлению антибиотиков происходит вытеснение чувствительных к ним штаммов данного вида, а антибиотикоустойчивые варианты выживают и начинают играть главную роль в эпидемиологии данного заболевания. Именно они и становятся источниками формирования тех клонов бактерий, которые обеспечивают эпидемическое распространение возбудителя. Решающую роль в распространении лекарственной устойчивости, в том числе множественной, играют R-плазмиды благодаря способности их к самопереносу.
Биохимические основы антибиотикорезистентности
Можно выделить следующие пять биохимических механизмов формирования резистентности:
-
Разрушение молекулы антибиотика. Такой механизм лежит главным образом в основе формирования устойчивости к бета-лактамным антибиотикам. Бета-лактамазы, разрушая структуру пенициллинов и цефалоспоринов, обеспечивают устойчивость к ним бактерий.
-
Модификация структуры молекулы антибиотика, в результате которой утрачивается ее биологическая активность. Гены, содержащиеся в R-плазмидах, кодируют белки, которые вызывают различные модификации молекул антибиотика путем их ацетилирования, фосфорилирования или аденилирования. Именно таким путем инактивируются аминогликозиды, макролиды, хлорамфеникол, клиндамицин и другие антибиотики. Существуют целые семейства генов, определяющих инактивацию того или иного антибиотика даже по одному из указанных выше механизмов. Например, среди клинических штаммов грамположительных и грамотрицательных бактерий обнаружены различные изоферменты аминогликозидфосфо-, -ацетил- и -аденил-трансфераз, обеспечивающие устойчивость бактерий к различным спектрам ами-ногликозидных антибиотиков.
-
Изменение структуры чувствительных к действию антибиотиков мишеней. Изменение структуры белков рибосом 70S лежит в основе устойчивости к стрептомицину, аминогликозидам, макролидам, тетрациклинам и другим антибиотикам. Изменение структуры бактериальных гираз в результате мутации приводит к формированию устойчивости к хинолонам; РНК-полимераз к рифампицину; пенициллинсвязыва-ющих белков (транспептидаз) к бета-лактамам и т. п.
-
Образование бактериями «обходного» пути метаболизма для биосинтеза белка-мишени, который оказывается нечувствительным к данному химиопрепарату, механизм, который лежит в основе резистентности к сульфаниламидным препаратам.
-
Формирование механизма активного выведения из клетки антибиотика, в результате чего он не успевает достичь своей мишени (один из вариантов устойчивости к тетрациклинам).
З А Н Я Т И Е 14
Дата ______________
Тема: Инфекционный процесс. Изучение факторов патогенности бактерий. Биологический метод диагностики.
План занятия:
1. Факторы патогенности. Экзотоксины.
а) Определение экзотоксина реакцией преципитации в геле. Демонстрация.
б) Мембраноповреждающие токсины (разрушают эритроциты, лейкоциты, тромбоциты, мастоциты, клетки культур тканей, протопласты и др.). Определение повреждающего действия на эритроциты (гемотоксина).
в) Определение некротоксического действия мембраноповреждающего токсина с помощью внутрикожной пробы на лабораторных животных - дермонекротическая проба. Демонстрация.
2. Факторы патогенности. Эндотоксин. Определение эндотоксина пробой на кролике. Демонстрация.
3. Факторы патогенности. Ферменты.
а) Гиалуронидаза. Определение гиалуронидазы - фактора проникновения в опыте на кролике. Демонстрация.
б) Фибринолизин. Определение фибринолизина на средах с плазмой крови. Разбор методики.
в) Плазмокоагулаза. Определение плазмокоагулазы, демонстрация опыта.
г) Лецитиназа. Определение лецитиназы на желточных средах. Демонстрация.
4. Методы заражения экспериментальных животных. Заражение белой мыши.
Методические указания
1. а) Определение дифтерийного экзотоксина реакцией преципитации в агаре.
Полоска фильтровальной бумаги размером 1,5x8 см, простерилизованная в автоклаве, пропитывается антитоксической противодифтерийной сывороткой "Диаферм-3", разведенной физиологическим раствором до содержания 500 АЕ в I мл.
Смоченную сывороткой бумагу стерильным пинцетом переносят на поверхность питательной среды в чашке Петри. Чашку подсушивают в термостате 20 минут. Испытуемые культуры (колонии) засевают петлей бляшками диаметром в I см на расстоянии 0,5 см от бумаги. На одну чашку засевают несколько штаммов, в том числе один заведомо токсигенный. Рекомендуется каждую культуру засевать не менее чем четырьмя бляшками (по две с каждой стороны от бумаги). Посевы помещают в термостат. Учет производят через 24, 48, 72 часа. Определение токсигенности основано на следующем принципе: образующийся в процессе роста дифтерийных бактерий экзотоксин диффундирует в питательную среду. Одновременно в среду диффундирует специфическая антитоксическая противодифтерийная сыворотка. В тех местах среды, где токсин и антитоксин встречаются в оптимальных соотношениях, выпадает реакция преципитации в виде белой изогнутой линии. Исследуемые бактерии считаются токсигенными, если линии преципитата их сливаются с линиями преципитата контрольного штамма. Демонстрация опыта по определению токсина методом преципитации в агаре.
б) Для определения гемотоксина произвести посев золотистого, стафилококка на пластинки кровяного МПА. Для этого чашка с кровяным МПА делится на два сектора. На одном из них засевается культура золотистого стафилококка, а на другом - для контроля - культура нетоксигенного белого стафилококка.
в) Определение некротоксина производится путем внутрикожного введения лабораторному животному 0,2 мл бульонной культуры (или фильтрата бульонной культуры) испытуемого микроба.
Через сутки или двое суток на месте введения образуется очаг некроза. Демонстрация опыта. Зарисовать дермонекротическую пробу.
2. Демонстрация опыта по выявлению брюшнотифозного эндотоксина внутрикожной пробы на кролике. 0,2 мл эндотоксина, полученного путем обработки культуры трихлоруксусной кислотой, вводят внутрикожно кролику. На месте введения эндотоксина через 24-48 часов отмечается воспалительная реакция. Зарисовать.
3. а) Для выявления гиалуронидазы кролику в один участок депилированной кожи вводят внутрикожно 0,2 мл туши в физиологическом растворе, а в такой же соседний участок - 0,2 мл туши с прибавлением фильтрата бульонной культуры стафилококка.
Пятно на месте инъекции туши с фильтратом бульонной культуры стафилококка через 24-48 часов в несколько раз превосходит по размерам пятно на месте введения туши без фильтрата за счет повышения проницаемости ткани в присутствии гиалуронидазы. Демонстрация опыта.
б) Для выявления фибринолитического фермента в чашки Петри с агаровой средой, содержащей плазму, засевают испытуемую культуру. После инкубации в течение 24-48 часов при 37 °C образуется зона просветления вокруг колоний бактерий, продуцирующих фибринолизин. Демонстрация опыта.
в) Для выявления фермента плазмокоагулазы испытуемую культуру засевают в 0,2 мл цитратной кроличьей или человеческой плазмы. В случае выработки плазмокоагулазы через 2-4-6-18 часов инкубации при 37 °C происходит свертывание плазмы. В контроле плазма остается жидкой. Демонстрация опыта.
г) Для выявления лецитиназы изучаемую культуру засевают на желточный агар. При наличии лецитиназы вокруг колонии бактерий образуется зона помутнения и радужного венчика. Демонстрация опыта.
4. Демонстрация различных методов заражения экспериментальных животных:
а) подкожный способ заражения кролика и белой мыши;
б) внутрикожный способ заражения кролика и морской свинки; в)накожный способ заражения морской свинки;
г) внутривенный способ заражения кролика и белой мыши;
д) внутрибрюшинный способ заражения морской свинки и белой мыши.
Промикроскопироватъ культуру палочки Фридлендера с косячка МПА, окрасить препарат по Граму (по Ионэ), проверить чистоту культуры. Если культура чистая, приготовить из нее взвесь. Для этого стерильной пипеткой добавить в пробирку с культурой 5 мл стерильного физиологического раствора и вращением пробирки между ладонями рук смыть культуру; 0,2 мл полученной взвеси ввести внутрибрюшинно белой мыши. Зараженное животное маркировать краской и поместить в специальную банку.
Окраска капсул по Ионэ. На приготовленный и зафиксированный в жидком фиксаторе мазок наливаю 2%-ный раствор генцианвиолета и окрашивают в течение 3-х минут при легком подогревании над пламенем горелки. Затем сливают краску и наносят на препарат I %-ный раствор уксусной кислоты на 10 секунд (стекло необходимо покачивать). Препарат промывают водой, сушат и микроскопируют под иммерсией. Тела бактериальных клеток и фон окрашивается в фиолетовый цвет, капсулы не окрашиваются. Препарат зарисовать.
|
|
|
|
Определение экзотоксина реакцией преципитации в агаре |
Палочка Фридлендера Klebsiella pneumoniae Окраска____________ |
Контрольные вопросы
Что такое экзотоксин?
Что такое эндотоксин?
Каковы основные свойства экзотоксинов?
Каковы основные свойства эндотоксинов?
Какова химическая природа экзо- и эндотоксинов?
Что произойдет с экзотоксином, если его обработать формалином? Какие методы используются для обнаружения экзотоксинов?
Как называются бактерии, способные образовывать экзотоксин? Каков механизм действия гемотоксина, как можно обнаружить его присутствие?
На чем основан метод определения токсина в геле (агаре)?
Какие методы используются для обнаружения эндотоксинов?
Как определяется сила действия экзотоксина? Что такое минимальная смертельная доза, DL50?
Какие факторы патогенности (кроме токсинов) вы знаете?
Что такое патогенность и вирулентность микробов? Какие ферменты могут играть роль факторов патогенности? Какой фермент содержится в факторе распространения? Его действие на соединительную ткань?
С какой целью производится заражение лабораторных животных? Какие способы заражения животных Вы знаете?
Как маркируются подопытные животные и как они содержатся?
Какие меры предосторожности следует соблюдать при заражении животных?
Как производится подготовка животных к опыту?
Как осуществляется наблюдение за подопытными животными?
Приложение к ЗАНЯТИЮ 14.